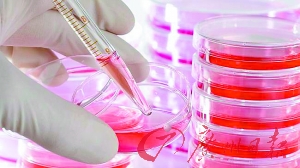

日本为促生育出大招 设“冻卵补贴”
越来越多日本女性关注冷冻卵子技术。

浦安市位于东京以东,是东京迪士尼乐园所在地。
为了提高生育率、逆转人口减少的趋势,日本政府近年来频出“大招”。
首都东京附近的浦安市政府宣布设立“冻卵补贴”,帮助暂时不想生育的女性居民冷冻卵子,以便她们在日后仍然能生育自己的孩子。
千叶县浦安市为逆转生育率不断降低的趋势,当地政府推出“冷冻卵子补贴”,成为日本首个设立这项补贴的地方政府。2007年的统计数据显示,当地人口约为16万人。
根据这项补贴计划,浦安市将在2018年3月前花费9000万日元(约合514万元人民币),为当地女性居民提出冷冻卵子的补贴。
按当地政府的说法,通常情况下,每名女性完成冷冻卵子的全部步骤,包括取卵、冷冻和封存等,所需费用在50万日元(约合2.86万元人民币)到60万日元(3.43万元人民币)之间。而有了这项补贴后,每名女性个人支付费用降到了约10万日元(5710元人民币)。
冷冻卵子受孕的几率“不高”
浦安市政府同时对申领“冻卵补贴”女性年龄提出了要求。申领补贴的女性年龄必须在20至35岁之间,而且应在45岁之前使用冷冻的卵子完成受孕。
早在去年7月,浦安市政府就与顺天堂大学附属浦安医院合作,就冷冻卵子课题展开研究。消息人士透露,这家医院已就冷冻卵子和晚育危害等问题举办多场讲座,共有约40名女性参加。
其中,已有4名女性提出申领“冻卵补贴”,并得到该医院伦理委员会批准。她们将成为首批成功申领这一补贴的女性。
随着越来越多日本人选择晚婚,日本女性首次生育年龄也不断推迟。日本政府数据显示,2014年该国女性首次生育平均年龄为30.6岁。同时,冷冻卵子也得到更多女性关注。
但针对健康女性冷冻卵子话题,专家们持不同看法。日本生殖医学学会对此表示赞同,并发布了相关指南。但日本妇产科学会则认为通过冷冻卵子受孕的几率“不高”,对此表示“不推荐”。
每对夫妇生2.1孩才够
日本虽是世界排名第10位的“人口大国”,但人口减少形势严峻。日本政府上月公布的统计数据显示,2015年日本人口总数为1.27亿。这是自1920年开始实施该项统计以来,日本人口总数首次出现减少的情况。
日本总务省预计,随着老龄人口死亡人数不断增加,人口自然减少率将持续增高。虽然在日居住的外国人呈现增加态势,但远无法弥补人口自然减少的缺口,日本人口将以每年20万的速度递减。
为阻止少子老龄化趋势,日本首相安倍晋三去年9月底提出“建设一亿总活跃社会”的施政目标,希望通过一系列措施提高生育率,使日本人口50年后仍维持在1亿水平。日本政府希望,能把每对夫妇平均生育子女数量由目前的1.42提高到1.8。
但一些经济学家认为,安倍政府把每对夫妇平均生育子女数量提高到1.8的计划仍然不够。根据这些专家的说法,日本应把这一数字提高至2.1才能维持人口总量平稳。
